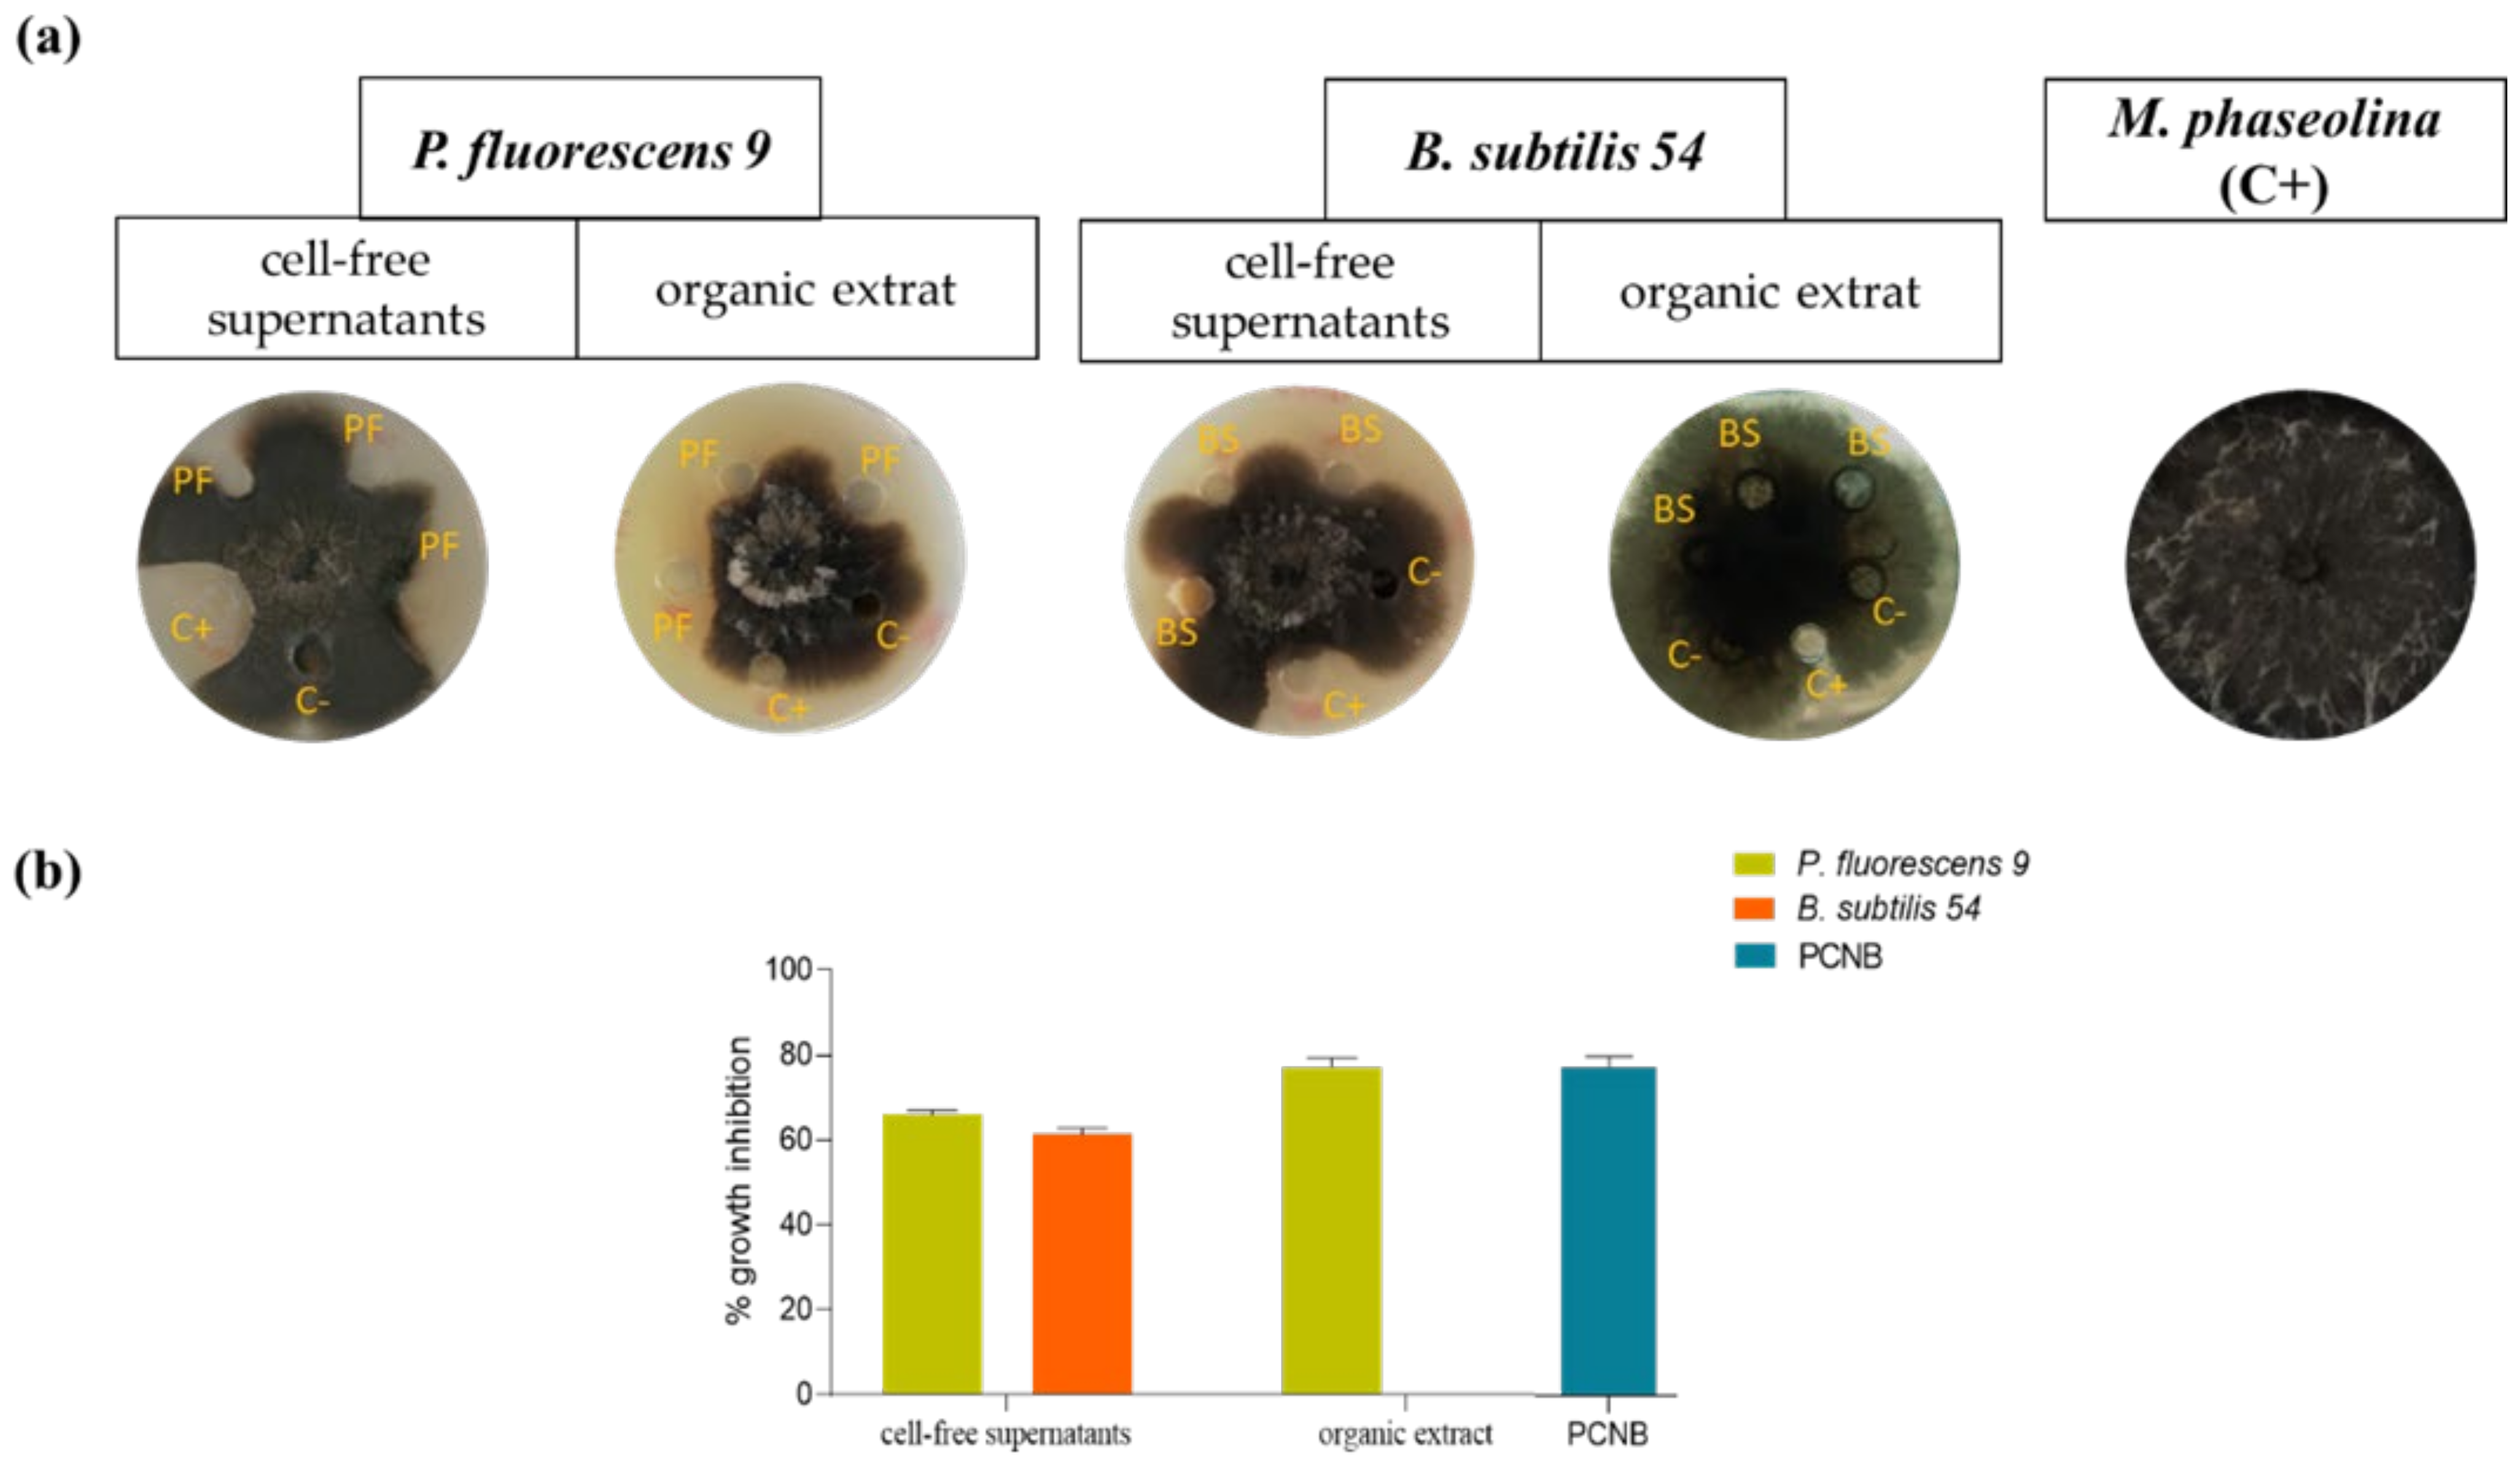
Biomolecules 11 01728 g001 Biomolecules 11 01728 g001
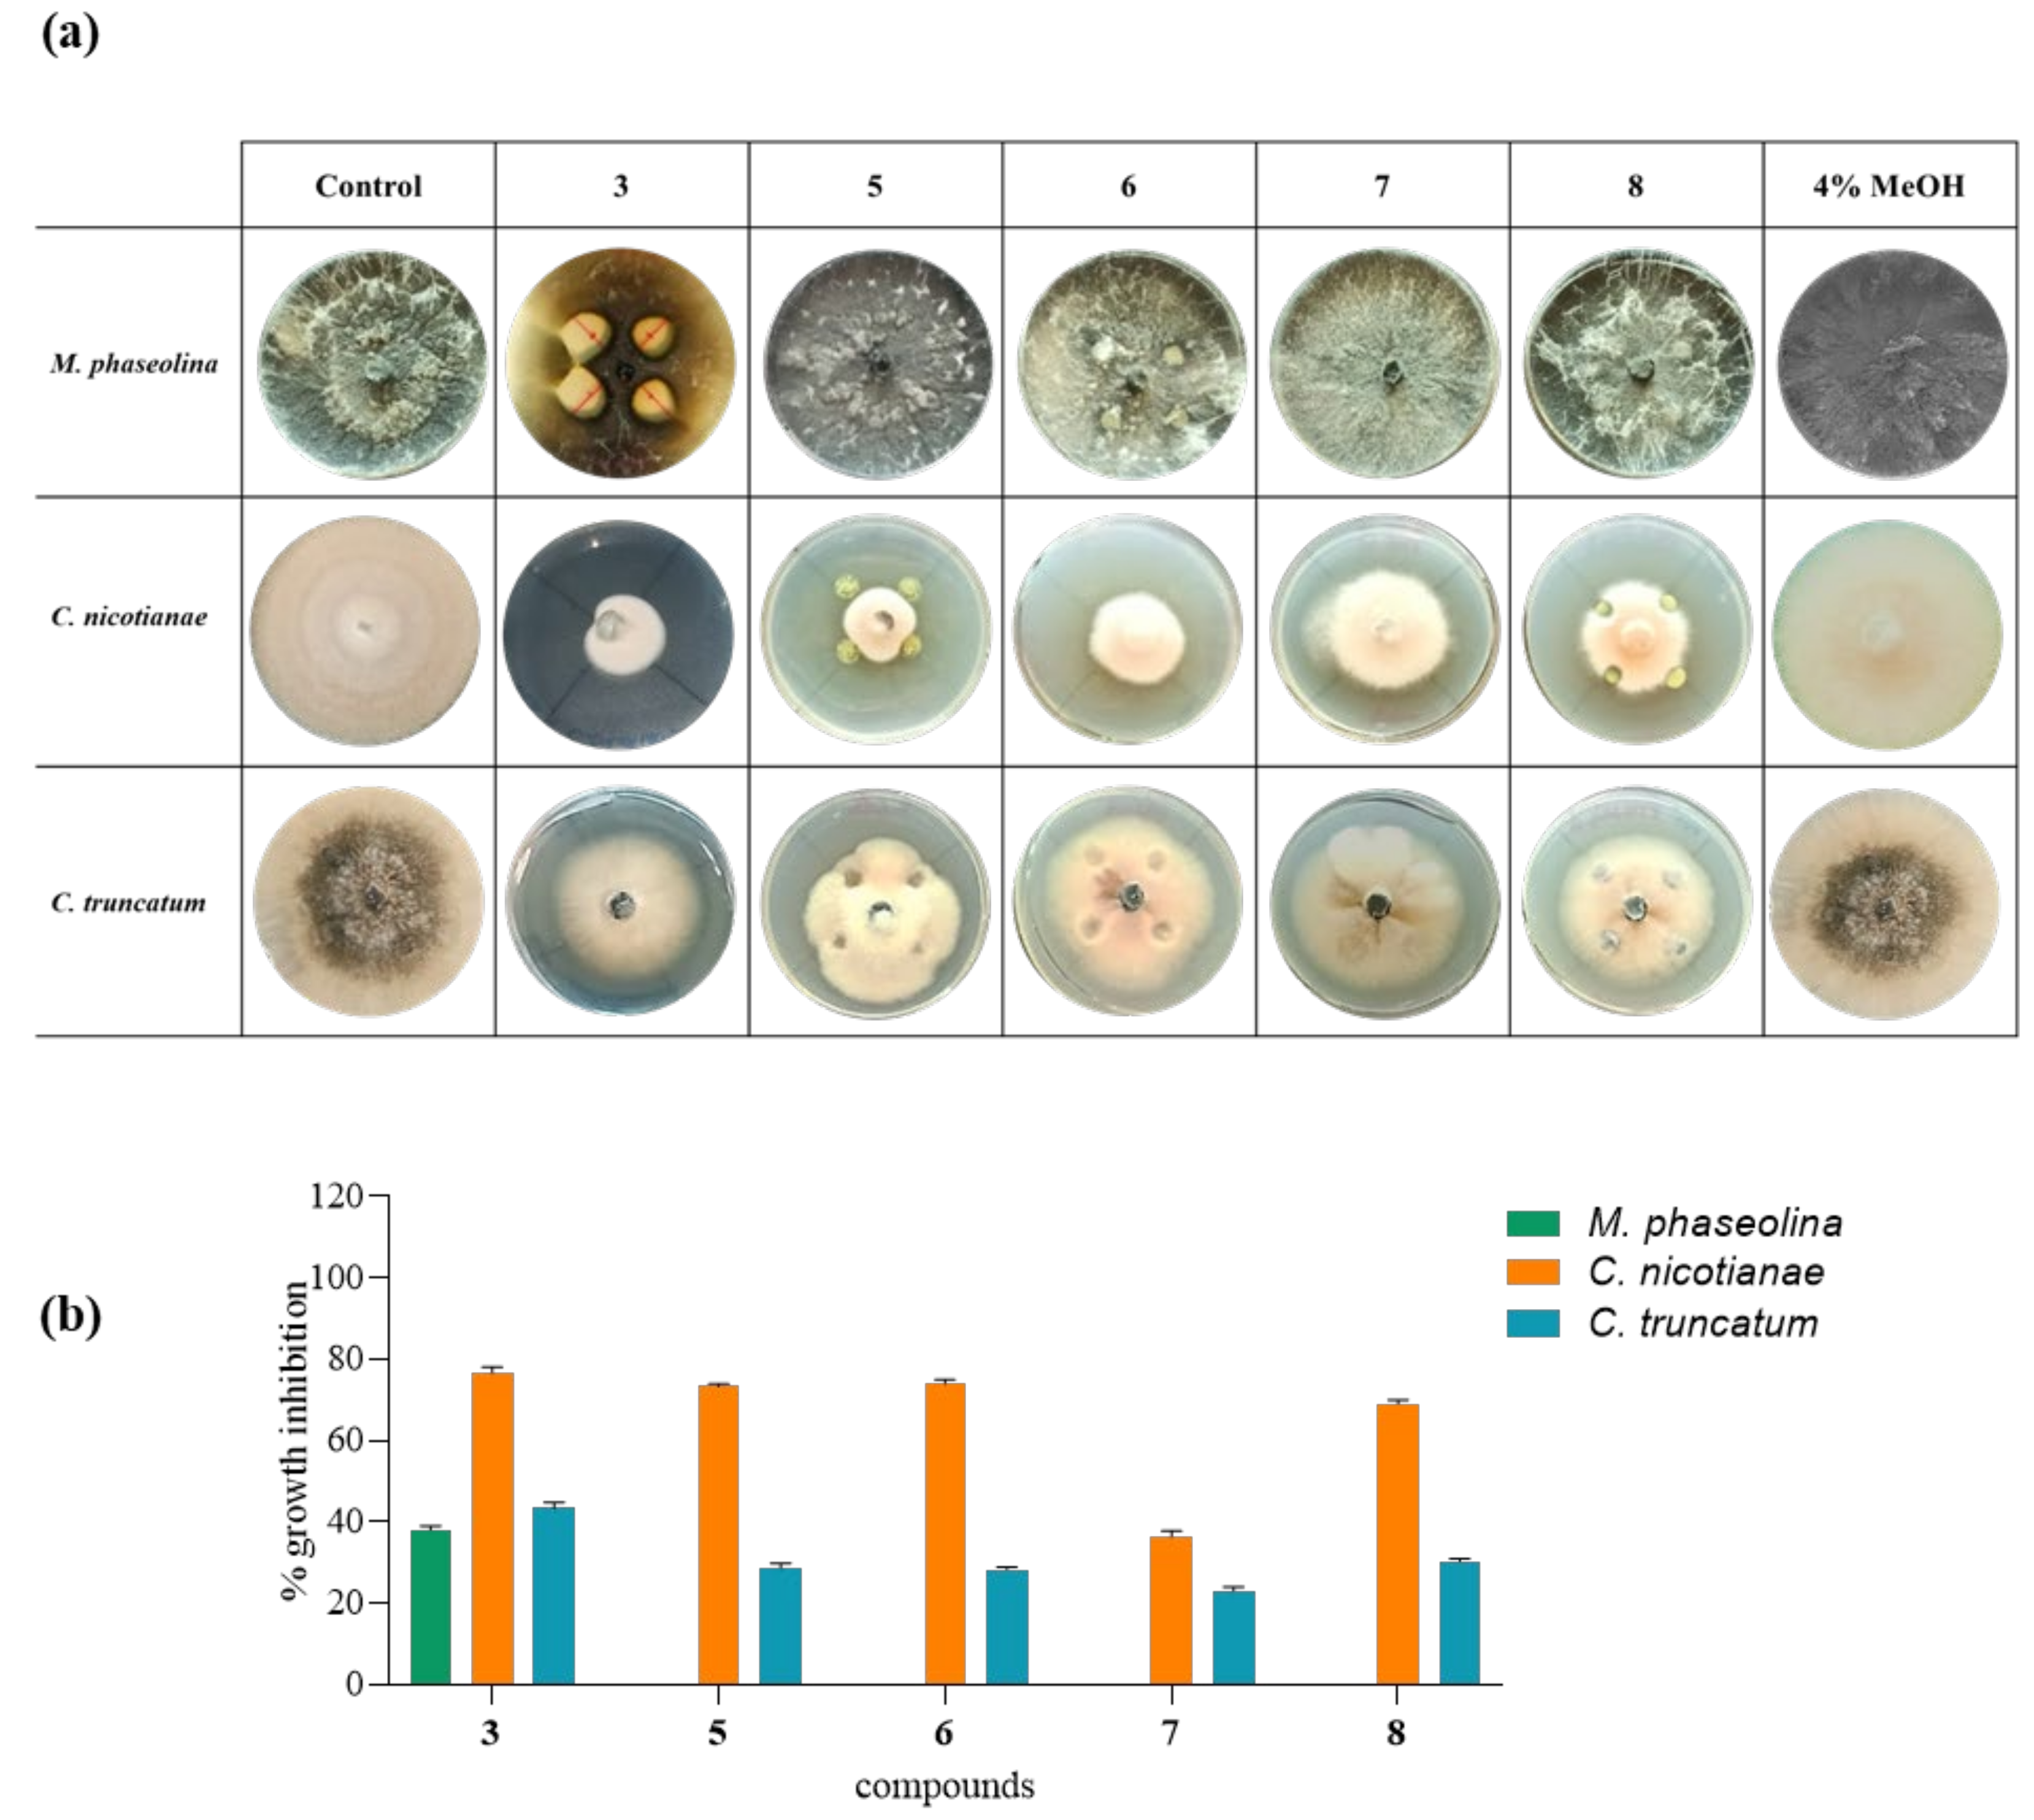
Biomolecules 11 01728 g007 Biomolecules 11 01728 g007

Pseudomonas fluorescens Showing Antifungal Activity against Macrophomina phaseolina, a Severe Pathogenic Fungus of Soybean, Produces Phenazine as the Main Active Metabolite
Abstract
1. Introduction
2. Materials and Methods
2.1. General Experimental Procedures
2.2. Bacterial and Fungal Strains
2.3. Cell-Free Supernatants
2.4. Production, Extraction, and Purification of Metabolites from Pseudomonas Fluorescens 9 and Production of the Crude Extract of Bacillus subtilis 54
- Phenazine (1): yellow amorphous solid, 1H-NMR δ: 8.29 (4H, dd, J = 6.5 and 3.3 Hz), 7.88 (4H, dd, J = 6.5 and 3.3 Hz). ESI MS (+) m/z: 181 [M + H]+.
- Mesaconic acid (2): white crystals, 1H-NMR (CD3OD) δ: 6.76 (1H, q, J = 1.4 Hz), 2.23 (3H, d, J = 1.4 Hz). ESI MS (−): m/z 129 [M − H]−.
2.5. Nitration of Phenazine
- 2-Nitrophenazine (5): yellow amorphous solid, 1H-NMR δ: 9.24 (1H, d, J = 3.4 Hz, H-1), 8.60 (1H, dd, J = 9.5 and 3.4 Hz, H-3), 8.43 (1H, d, J = 9.5 Hz, H-4), 8.33 (2H, m, H-6 and H-9), 7.99 (2H, m, H-7 and H-8), Figure S1. ESI MS (+) m/z: 226 [M + H]+.
- 1,3-Dinitrophenazine (6): yellow amorphous solid, 1H-NMR δ: 9.28 (1H, d, J = 2.2 Hz, H-4), 9.26 (1H, d, J = 2.2 Hz, H-2), 8.70 (2H, m, H-7 and H-8), 8.51 (2H, m, H-6 and H-9), Figure S2. ESI MS (+) m/z: 271 [M + H]+, ESI MS (−) m/z: 269 [M − H]−.
- 1,9-Dinitrophenazine (7): yellow amorphous solid, 1H-NMR δ: 8.60 (2H, br d, J = 8.6 Hz, H-4 and H-6), 8.30 (2H, dd, J = 7.7 and 1.2 Hz, H-2 and H-8), 8.04 (2H, m, H-3 and H-7), Figure S3. ESI MS (+) m/z: 271 [M + H]+, ESI MS (−) m/z: 269 [M − H]−.
- 2,9-Dinitrophenazine (8): yellow amorphous solid, 1H-NMR δ: 9.26 (1H, d, J = 2.5 Hz, H-1), 8.69 (1H, dd, J = 9.0 and 2.5 Hz, H-3), 8.59 (1H, br d, J = 8.9 Hz H-6), 8.53 (1H, d, J = 9.0 Hz, H-4), 8.39 (1H, br d, J = 8.9 Hz, H-8), 8.04 (1H, t, J = 8.9 Hz, H-7), Figure S4. ESI MS (+) m/z: 271 [M + H]+, ESI MS (−) m/z: 269 [M − H]−.
2.6. Crystal Structure Determination of Mesaconic Acid (2)
2.7. Antifungal Assay
2.8. Minimal Inhibitory Concentration (MIC50)
2.9. Data Analysis
3. Results and Discussion
Supplementary Materials
Author Contributions
Funding
Institutional Review Board Statement
Informed Consent Statement
Data Availability Statement
Acknowledgments
Conflicts of Interest
References
- Tilman, D.; Balzer, C.; Hill, J.; Befort, B.L. Global food demand and the sustainable intensification of agriculture. Proc. Natl. Acad. Sci. USA 2011, 108, 20260–20264. [Google Scholar] [CrossRef]
- The Future of Food and Agriculture-Trends and Challenges; FAO: Rome, Italy, 2017.
- Rosegrant, M.W.; Cline, S.A. Global food security: Challenges and policies. Science 2003, 302, 1917–1919. [Google Scholar] [CrossRef]
- Foley, J.A.; Ramankutty, N.; Brauman, K.A.; Cassidy, E.S.; Gerber, J.S.; Johnston, M.; Mueller, N.D.; O’Connell, C.; Ray, D.K.; West, P.C.; et al. Solutions for a cultivated planet. Nature 2001, 478, 337–342. [Google Scholar] [CrossRef] [PubMed]
- Ballio, A.; Graniti, A. Phytotoxins and their involvement in plant disease. Experientia 1991, 47, 751–864. [Google Scholar] [CrossRef]
- Evidente, A.; Cimmino, A.; Masi, M. Phytotoxins produced by pathogenic fungi of agrarian plants. Phytochem. Rev. 2019, 18, 843–870. [Google Scholar] [CrossRef]
- Islam, M.S.; Haque, M.S.; Islam, M.M.; Emdad, E.M.; Halim, A.; Hossen, Q.M.M.; Hossain, M.Z.; Ahmed, B.; Rahim, S.; Rahman, M.S.; et al. Tools to kill: Genome of one of the most destructive plant pathogenic fungi Macrophomina phaseolina. BMC Genom. 2012, 13, 493. [Google Scholar] [CrossRef] [PubMed]
- Marquez, N.; Giachero, M.L.; Declerck, S.; Ducasse, D.A. Macrophomina phaseolina: General characteristics of pathogenicity and methods of control. Front. Plant Sci. 2021, 12, 634397. [Google Scholar] [CrossRef] [PubMed]
- Su, G.; Suh, S.O.; Schneider, R.W.; Russin, J.S. Host specialization in the charcoal rot fungus, Macrophomina phaseolina. Phytopathology 2001, 91, 120–126. [Google Scholar] [CrossRef]
- Farnaz, A.A.; Narmani, A.; Arzanlou, M. Macrophomina phaseolina associated with grapevine decline in Iran. Phytopat. Mediterr. 2018, 57, 107–111. [Google Scholar] [CrossRef]
- Gupta, S.; Chandran, R.R.; Divekar, P.V. Botryodiplodin—A new antibiotic from Botryodiplodia theobromae. II. Production, isolation and biological properties. Indian Exp. J. Biol. 1966, 4, 152–153. [Google Scholar] [CrossRef]
- Dhar, T.K.; Siddiqui, K.A.; Ali, E. Structure of phaseolinone, a novel phytotoxin from Macrophomina phaseolina. Tetrahedron Lett. 1982, 23, 5459–5462. [Google Scholar] [CrossRef]
- Masi, M.; Sautua, F.; Zatout, R.; Castaldi, S.; Arrico, L.; Isticato, R.; Pescitelli, G.; Carmona, M.A.; Evidente, A. Phaseocyclopentenones A and B, phytotoxic penta- and tetra-substituted cyclopentenones produced by Macrophomina phaseolina, the causal agent of charcoal rot of soybean in Argentina. J. Nat. Prod. 2021, 84, 459–465. [Google Scholar] [CrossRef]
- Carmona, M.; Sautua, F.; Scandiani, M.; Bello, R.; Lopez, V.; Luque, A. In vitro sensitivity assessment of late season soybean pathogens to fungicide mixtures. Australas. Plant Dis. Notes 2017, 12, 1–4. [Google Scholar] [CrossRef]
- Sautua, F.J.; Doyle, V.P.; Price, P.P.; Porfiri, A.; Fernandez, P.; Scandiani, M.M.; Carmona, M.A. Fungicide resistance in Cercospora species causing cercospora leaf blight and purple seed stain of soybean in Argentina. Plant Pathol. 2020, 69, 1678–1694. [Google Scholar] [CrossRef]
- Dias, M.D.; Pinheiro, V.F.; Café-Filho, A.C. Impact of anthracnose on the yield of soybean subjected to chemical control in the north region of Brazil. Summa Phytopathol. 2016, 42, 18–23. [Google Scholar] [CrossRef]
- Poti, T.; Mahawan, K.; Cheewangkoon, R.; Arunothayanan, H.; Akimitsu, K.; Nalumpang, S. Detection and molecular characterization of carbendazim-resistant Colletotrichum truncatum isolates causing anthracnose of soybean in Thailand. J. Phytopathol. 2020, 168, 267–278. [Google Scholar] [CrossRef]
- Guimarães, G.R. Morfologia, Patogenicidade e Sensibilidade à Fungicidas de Isolados de Colletotrichum truncatum (Schw.) Andrus & WD Moore. Ph.D. Thesis, Universidade Federal de Uberlândia, Uberlândia, Brazil, 2021. [Google Scholar] [CrossRef]
- Simonetti, E.; Viso, N.P.; Montecchia, M.; Zilli, C.; Balestrasse, K.; Carmona, M. Evaluation of native bacteria and manganese phosphite for alternative control of charcoal root rot of soybean. Microbiol. Res. 2015, 180, 40–48. [Google Scholar] [CrossRef] [PubMed]
- Castaldi, S.; Petrillo, C.; Donadio, G.; Piaz, F.D.; Cimmino, A.; Masi, M.; Evidente, A.; Isticato, R. Plant growth promotion function of Bacillus sp. strains isolated from salt-pan rhizosphere and their biocontrol potential against Macrophomina phaseolina. Int. J. Mol. Sci. 2021, 24, 3324. [Google Scholar] [CrossRef]
- Puopolo, G.; Masi, M.; Raio, A.; Andolfi, A.; Zoina, A.; Cimmino, A.; Evidente, A. Insights on the susceptibility of plant pathogenic fungi to phenazine-1-carboxylic acid and its chemical derivatives. Nat. Prod Res. 2013, 27, 956–966. [Google Scholar] [CrossRef]
- Raio, A.; Puopolo, G.; Cimmino, A.; Danti, R.; Della Rocca, G.; Evidente, A. Biocontrol of cypress canker by the phenazine producer Pseudomonas chlororaphis subsp. aureofaciens strain M71. Biol. Control 2011, 58, 133–138. [Google Scholar] [CrossRef]
- Raio, A.; Reveglia, P.; Puopolo, G.; Cimmino, A.; Danti, R.; Evidente, A. Involvement of phenazine-1-carboxylic acid in the interaction between Pseudomonas chlororaphis subsp. aureofaciens strain M71 and Seiridium cardinale in vivo. Microbiol. Res. 2017, 199, 49–56. [Google Scholar] [CrossRef] [PubMed]
- Yue, Y.; Yu, H.; Li, R.; Hu, L.; Liu, S.; Li, P. Isolation and identification of antimicrobial metabolites from sea anemone-derived fungus Emericella sp. SMA01. J. Oceanol. Limnol. 2021, 39, 1010–1019. [Google Scholar] [CrossRef]
- Mazlan, N.A.; Santhanam, J.; Zin, N.M.; Santiago, C. Effects of combination of phenazine-1-carboxylic acid from Streptomyces kebangsaanensis with amphotericin B on clinical Fusarium solani species. Malays. J. Microbiol. 2020, 16, 432–437. [Google Scholar]
- Halicki, P.C.B.; Nunes da Silva Júnior, E.; de Melo Jardim, G.A.; de Almeida, R.G.; de Menezes Vicenti, J.R.; Gonçalves, B.L.; Almeida da Silva, P.E.; Fernandes Ramos, D. Benzo [a] phenazine derivatives: Promising scaffolds to combat resistant Mycobacterium tuberculosis. Chem. Biol. Drug Des. 2021, 98, 352–362. [Google Scholar] [CrossRef] [PubMed]
- Altomare, A.; Burla, M.C.; Camalli, M.; Cascarano, G.L.; Giacovazzo, C.; Guagliardi, A.; Moliterni, A.G.G.; Polidori, G.; Spagna, R. SIR97: A new tool for crystal structure determination and refinement. J. Appl. Crystallogr. 1999, 32, 115–119. [Google Scholar] [CrossRef]
- Sheldrick, G.M. Crystal structure refinement with SHELXL. Acta Crystallogr. Sect. C Struct. Chem. 2015, 71, 3–8. [Google Scholar] [CrossRef]
- Gupta, M.P.; Yadav, S.R.P. The crystal structure of mesaconic acid, C5H6O4. Acta Crystallogr. Sect. B Struct. Sci. Cryst. 1972, 28, 2682–2686. [Google Scholar] [CrossRef]
- Rahman, M.M.; Hossain, D.M.; Suzuki, K.; Shiiya, A.; Suzuki, K.; Dey, T.K.; Nonaka, M.; Harada, N. Suppressive effects of Bacillus spp. on mycelia, apothecia and sclerotia formation of Sclerotinia sclerotiorum and potential as biological control of white mold on mustard. Australas. Plant Pathol. 2016, 45, 103–117. [Google Scholar] [CrossRef]
- Mefteh, F.B.; Daoud, A.; Chenari Bouket, A.; Alenezi, F.N.; Luptakova, L.; Rateb, M.E.; Kadri, A.; Gharsallah, N.; Belbahri, L. Fungal root microbiome from healthy and brittle leaf diseased date palm trees (Phoenix dactylifera L.) reveals a hidden untapped arsenal of antibacterial and broad spectrum antifungal secondary metabolites. Front. Microbiol. 2017, 28, 8–307. [Google Scholar] [CrossRef]
- Katsuki, H.; Ariga, N.; Katsuki, F.; Nagai, J.; Egashira, S.; Tanaka, S. Enzymic hydration of mesaconate by Pseudomonas fluorescens. Biochim. Biophys. Acta 1962, 56, 545–551. [Google Scholar] [CrossRef]
- Lardy, H.A. The metabolism of itaconic acid by liver mitochondria. J. Biol. Chem. 1957, 229, 865–879. [Google Scholar] [CrossRef]
- Laursen, J.B.; Nielsen, J. Phenazine natural products: Biosynthesis, synthetic analogues, and biological activity. Chem. Rev. 2004, 104, 1663–1686. [Google Scholar] [CrossRef] [PubMed]
- Cimmino, A.; Evidente, A.; Mathieu, V.; Andolfi, A.; Lefranc, F.; Kornienko, A.; Kiss, R. Phenazines and cancer. Nat. Prod. Rep. 2012, 29, 487–501. [Google Scholar] [CrossRef]
- Liu, T.T.; Ye, F.C.; Pang, C.P.; Yong, T.Q.; Tang, W.D.; Xiao, J.; Lu, Z.J. Isolation and identification of bioactive substance 1-hydroxyphenazine from Pseudomonas aeruginosa and its antimicrobial activity. Lett. Appl. Microbiol. 2020, 71, 303–310. [Google Scholar] [CrossRef] [PubMed]
- De Britto, S.; Gajbar, T.D.; Satapute, P.; Sundaram, L.; Lakshmikantha, R.Y.; Jogaiah, S.; Ito, S.I. Isolation and characterization of nutrient dependent pyocyanin from Pseudomonas aeruginosa and its dye and agrochemical properties. Sci. Rep. 2020, 10, 1–12. [Google Scholar] [CrossRef]
- Agaras, B.C.; Valverde, C.F. A mutation in the glta gene from a native isolate of the Pseudomonas chlororaphis subgroup induces a phenotypic change associated with phenazine production. Arch. Phytopatol. Plant Protect. 2019, 52, 601–624. [Google Scholar] [CrossRef]
- Karmegham, N.; Vellasamy, S.; Natesan, B.; Sharma, M.P.; Al Farraj, D.A.; Elshikh, M.S. Characterization of antifungal metabolite phenazine from rice rhizosphere fluorescent pseudomonads (FPs) and their effect on sheath blight of rice. Saudi J. Biol. Sci. 2020, 27, 3313–3326. [Google Scholar] [CrossRef]
- Carey, F.A.; Sundberg, R.J. Advanced Organic Chemistry: Part B: Reactions and Synthesis, 4th ed.; Kluwer Academic/Plenum: New York, NY, USA, 2003; Volume 80, pp. 880–883. [Google Scholar] [CrossRef][Green Version]

| MIC50 (µg/mL) | |||
|---|---|---|---|
| Compounds | M. phaseolina | C. nicotianae | C. truncatum |
| 3 | 35 µg/mL | 15 µg/mL | 25 µg/mL |
| 1 | 35 µg/mL | 15 µg/mL | 30 µg/mL |
| 5 | - | 20 µg/mL | 60 µg/mL |
| 6 | - | 20 µg/mL | 60 µg/mL |
| 7 | - | 40 µg/mL | 60 µg/mL |
| 8 | - | 20 µg/mL | 60 µg/mL |
Publisher’s Note: MDPI stays neutral with regard to jurisdictional claims in published maps and institutional affiliations. |
© 2021 by the authors. Licensee MDPI, Basel, Switzerland. This article is an open access article distributed under the terms and conditions of the Creative Commons Attribution (CC BY) license (https://creativecommons.org/licenses/by/4.0/).
Share and Cite
Castaldi, S.; Masi, M.; Sautua, F.; Cimmino, A.; Isticato, R.; Carmona, M.; Tuzi, A.; Evidente, A. Pseudomonas fluorescens Showing Antifungal Activity against Macrophomina phaseolina, a Severe Pathogenic Fungus of Soybean, Produces Phenazine as the Main Active Metabolite. Biomolecules 2021, 11, 1728. https://doi.org/10.3390/biom11111728
Castaldi S, Masi M, Sautua F, Cimmino A, Isticato R, Carmona M, Tuzi A, Evidente A. Pseudomonas fluorescens Showing Antifungal Activity against Macrophomina phaseolina, a Severe Pathogenic Fungus of Soybean, Produces Phenazine as the Main Active Metabolite. Biomolecules. 2021; 11(11):1728. https://doi.org/10.3390/biom11111728
Chicago/Turabian StyleCastaldi, Stefany, Marco Masi, Francisco Sautua, Alessio Cimmino, Rachele Isticato, Marcelo Carmona, Angela Tuzi, and Antonio Evidente. 2021. "Pseudomonas fluorescens Showing Antifungal Activity against Macrophomina phaseolina, a Severe Pathogenic Fungus of Soybean, Produces Phenazine as the Main Active Metabolite" Biomolecules 11, no. 11: 1728. https://doi.org/10.3390/biom11111728
APA StyleCastaldi, S., Masi, M., Sautua, F., Cimmino, A., Isticato, R., Carmona, M., Tuzi, A., & Evidente, A. (2021). Pseudomonas fluorescens Showing Antifungal Activity against Macrophomina phaseolina, a Severe Pathogenic Fungus of Soybean, Produces Phenazine as the Main Active Metabolite. Biomolecules, 11(11), 1728. https://doi.org/10.3390/biom11111728









